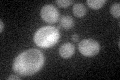
YKL184W
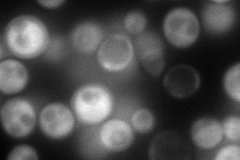
YKL184W
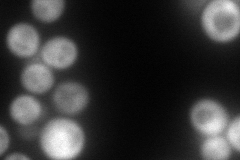
YKL184W
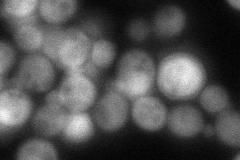
YKL184W
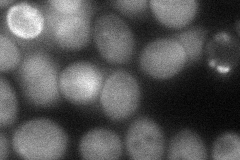
YKL184W
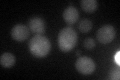
YKL184W

View description
Ornithine decarboxylase, catalyzes the first step in polyamine biosynthesis; degraded in a proteasome-dependent manner in the presence of excess polyamines; deletion decreases lifespan, and increases necrotic cell death and ROS generation
Localization:
Intensity:
Fold change:
Significance:
-
C’ GFP library in SD
cytosol33.11 -
N' NOP1pr-GFP in SD
cytosol157.161 -
N' TEF2pr-mCherry in SD
cytosol178.657 -
N' NATIVEpr-GFP in SD
cytosol60.3719 -
N' TEF2pr-VC and Cyto-VN in SD
cytosol60.8822 -
C’ GFP library in SD+DTT
cytosol21.940.66Yes -
C’ GFP library in SD+H2O2

cytosol32.860.99No -
C’ GFP library in Starvation Media

cytosol14.070.42No -
C’ GFP library on the background of Pup2-DaMP

cytosol -
C’ GFP library on the background of CCT mutant

cytosol43.39111.31016No
